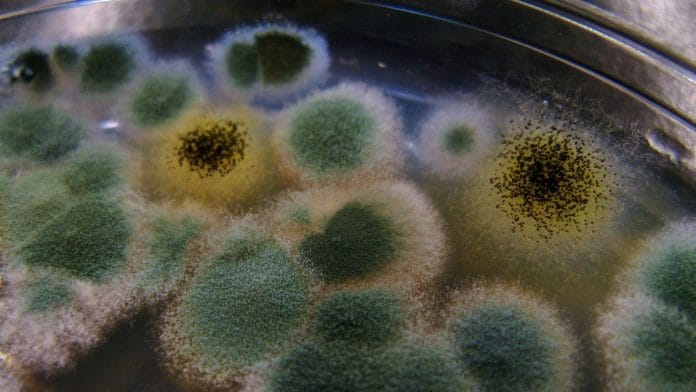
Penicillin G is produced by fermentation of Penicillium chrysogenum | Representational image | flickr

Bengaluru: The Union Minister for Health and Family Welfare, Mansukh Mandaviya, has announced that after a 30-year break, India will resume the production of the narrow spectrum antibiotic benzypenicillin or Penicillin G.
The drug is used to treat tetanus, strep infections, syphilis, pneumonia, and more.
Its production is set to resume under the central government’s Production-Linked Incentive (PLI) scheme that was launched to promote domestic manufacturing.
In the 1990s, the production of PenG was slowed down and stopped in India after cheaper alternatives began surfacing in the global market.
Other drugs, including paracetamol, started to have cheaper alternatives that could be imported, reducing the number of pharmaceutical drug manufacturers in India, said a report published in The Indian Express Friday, quoting industry experts.
The report added that there has been a decline in the imports of active pharmaceutical ingredients (APIs) such as paracetamol in India after the introduction of the PLI scheme.
Mandaviya announced the resumption of production of PenG on 2 March, when he virtually inaugurated 27 greenfield bulk drug park projects and 13 manufacturing plants for medical devices under the PLI scheme.
“The PLI scheme is a result of wide-ranging deliberations on India’s dependence on critical resources, risk to supply chain bottlenecks and the industry’s global competitiveness,” he said.
As with many other industries, disruptions to global supply chains during the first few years of the Covid-19 pandemic prompted India to launch a number of domestic production and startup schemes, through which PenG production will also resume in the country.
Mandaviya said that medicines are an essential requirement, and high dependency on imports of critical medical resources led to deliberations for the PLI scheme.
Also Read: 70% of antibiotic fixed-dose combination drugs sold in India unapproved or banned, finds study
Past manufacturing
On a global scale, India is often called the ‘pharmacy of the world’ due to large-scale production of drugs and generics, the latter of which makes up a fifth of the share of global generics.
While India is still the largest contributor by volume to generics, its active pharmaceutical ingredient or API industry has struggled to grow since the late 1980s and early 1990s.
India’s pharmaceutical industry was in 2022-23 valued at $50 billion, with nearly 50 percent of it coming from exports. The figure is expected to reach $130 billion by 2030.
Policy practices behind industrial licence granting, which promoted small industries, fragmented capacities and resulted in India manufacturing APIs to meet domestic demand only, the late D.G. Shah, founder of the Indian Pharmaceutical Alliance, wrote in 2016 in an article for The Economic Times. As a result, formulators started relying on imported APIs, especially from China, to meet their needs, he explained.
The shutdown of India’s efficient API industry affected products that required fermentation; thus also affecting the fermentation technology industry. APIs that began to be imported included those for paracetamol, aspirin, and vitamin C, among others. Drugs that require a fermentation process include PenG, erythromycin, and the anti-tuberculosis medicine rifampicin. Enzymes and hormones like insulin were also affected.
The last plant to manufacture PenG was in Ahmedabad, and several plants are expected to resume or start production soon. PenG is produced by fermentation of the fungus penicillium chrysogenum, followed by purification of the penicillin molecule. Benzylpenicillin is created as a product and extracted with sugars, salts, and yeast.
PenG is administered through an injection, either into the veins or into muscle. It is not available to be taken orally, and most forms of PenG are administered intramuscularly.
The PenG molecule can also lead to adverse effects like fever, rash, and in serious cases, convulsion and blood-clotting problems. It is also considered an environmental hazard due to its allergic nature.
PLI scheme
The PLI scheme aims to aid the biomedical and pharmaceutical industry by providing financial support for incremental sales by companies for more than five years.
Mandaviya said that under the PLI-1 scheme, 48 important bulk drugs were identified for domestic production. These include para-aminophenol, levofloxacin, valsartan, lopinavir, pednisolone, vitamin B6, norfloxacin, and more.
Additionally, medical devices plants inaugurated under the scheme aim to manufacture MRI coils, linear accelerators, CT scan equipment, oxygen concentrators, and more.
India’s medical devices industry, currently estimated to be worth $11 billion, is expected to reach $30 billion by 2050.
The PLI scheme carries a budget of Rs 3,420 crore for the years 2020 to 2028.
Under it, companies are given assistance at the rate of 5 percent of incremental sales of medical devices, such as cancer care equipment, imaging devices, critical care devices, and body implants. A total of 138 products are approved under the scheme.
A PLI-2 scheme is also under discussion, with a budget of Rs 15,000 crore, according to Mandaviya.
(Edited by Nida Fatima Siddiqui)
Also Read: Budget gives 200% boost to pharma sector as govt looks to curb dependence on China